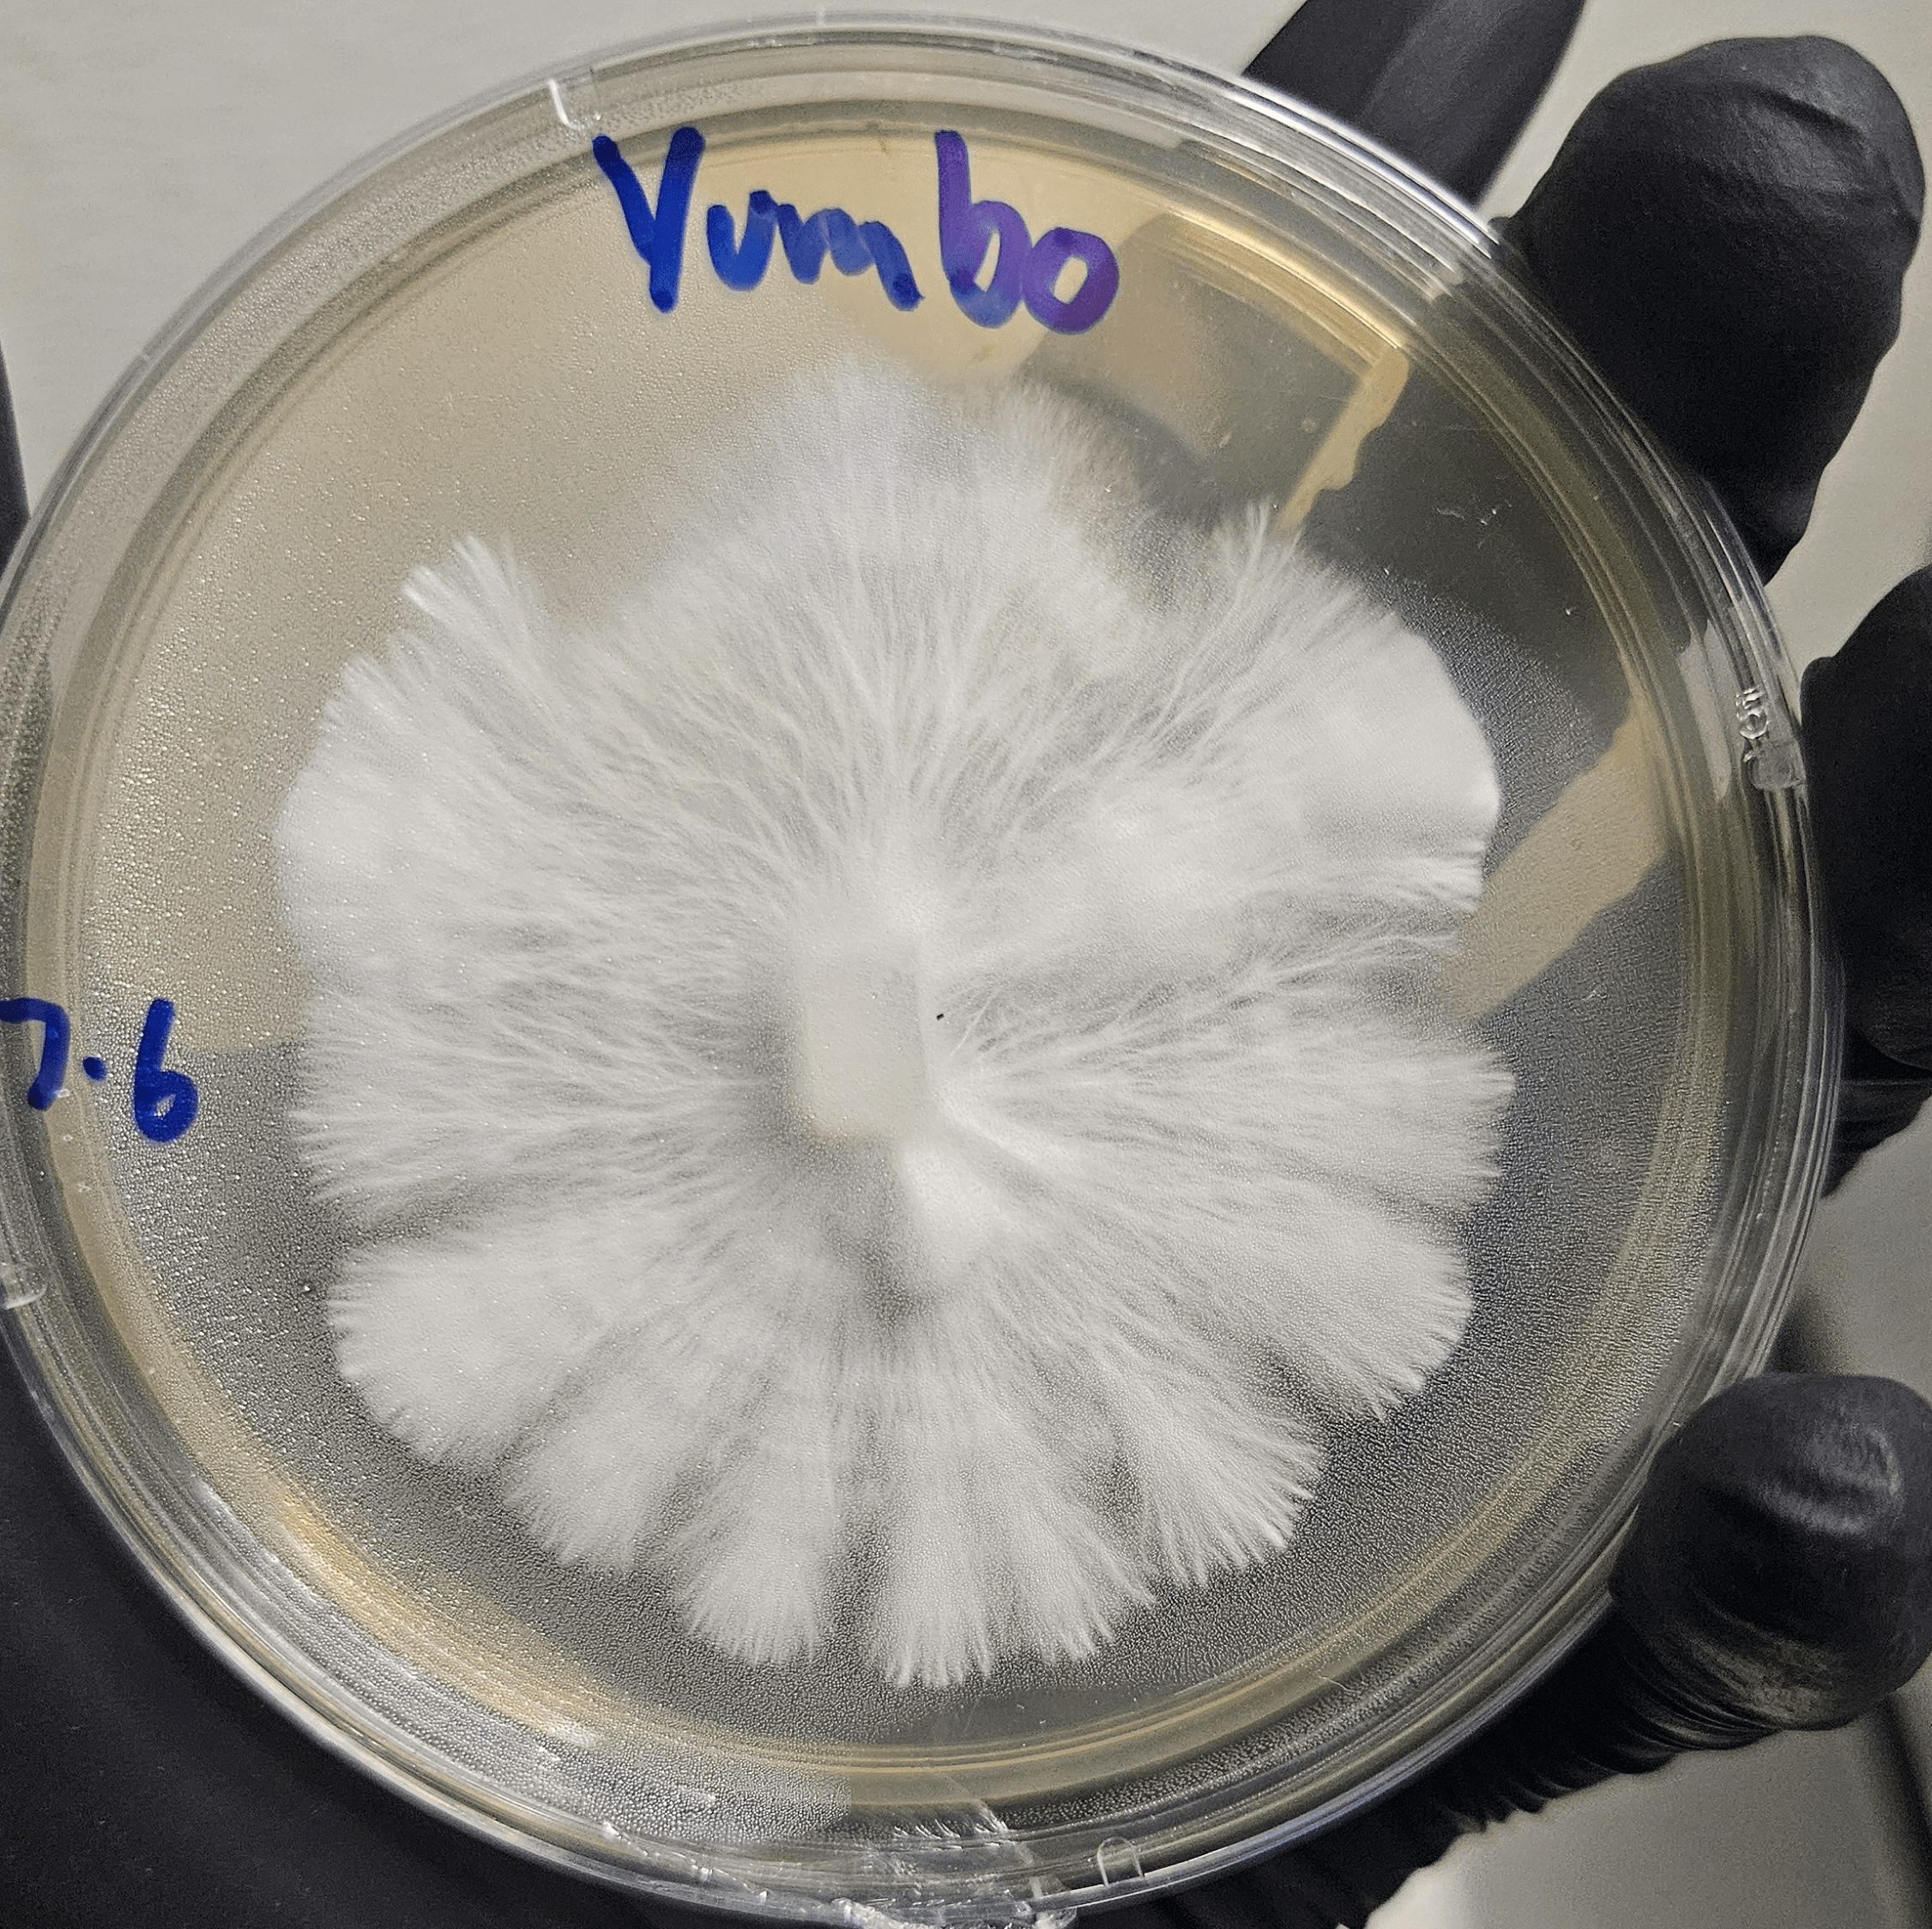
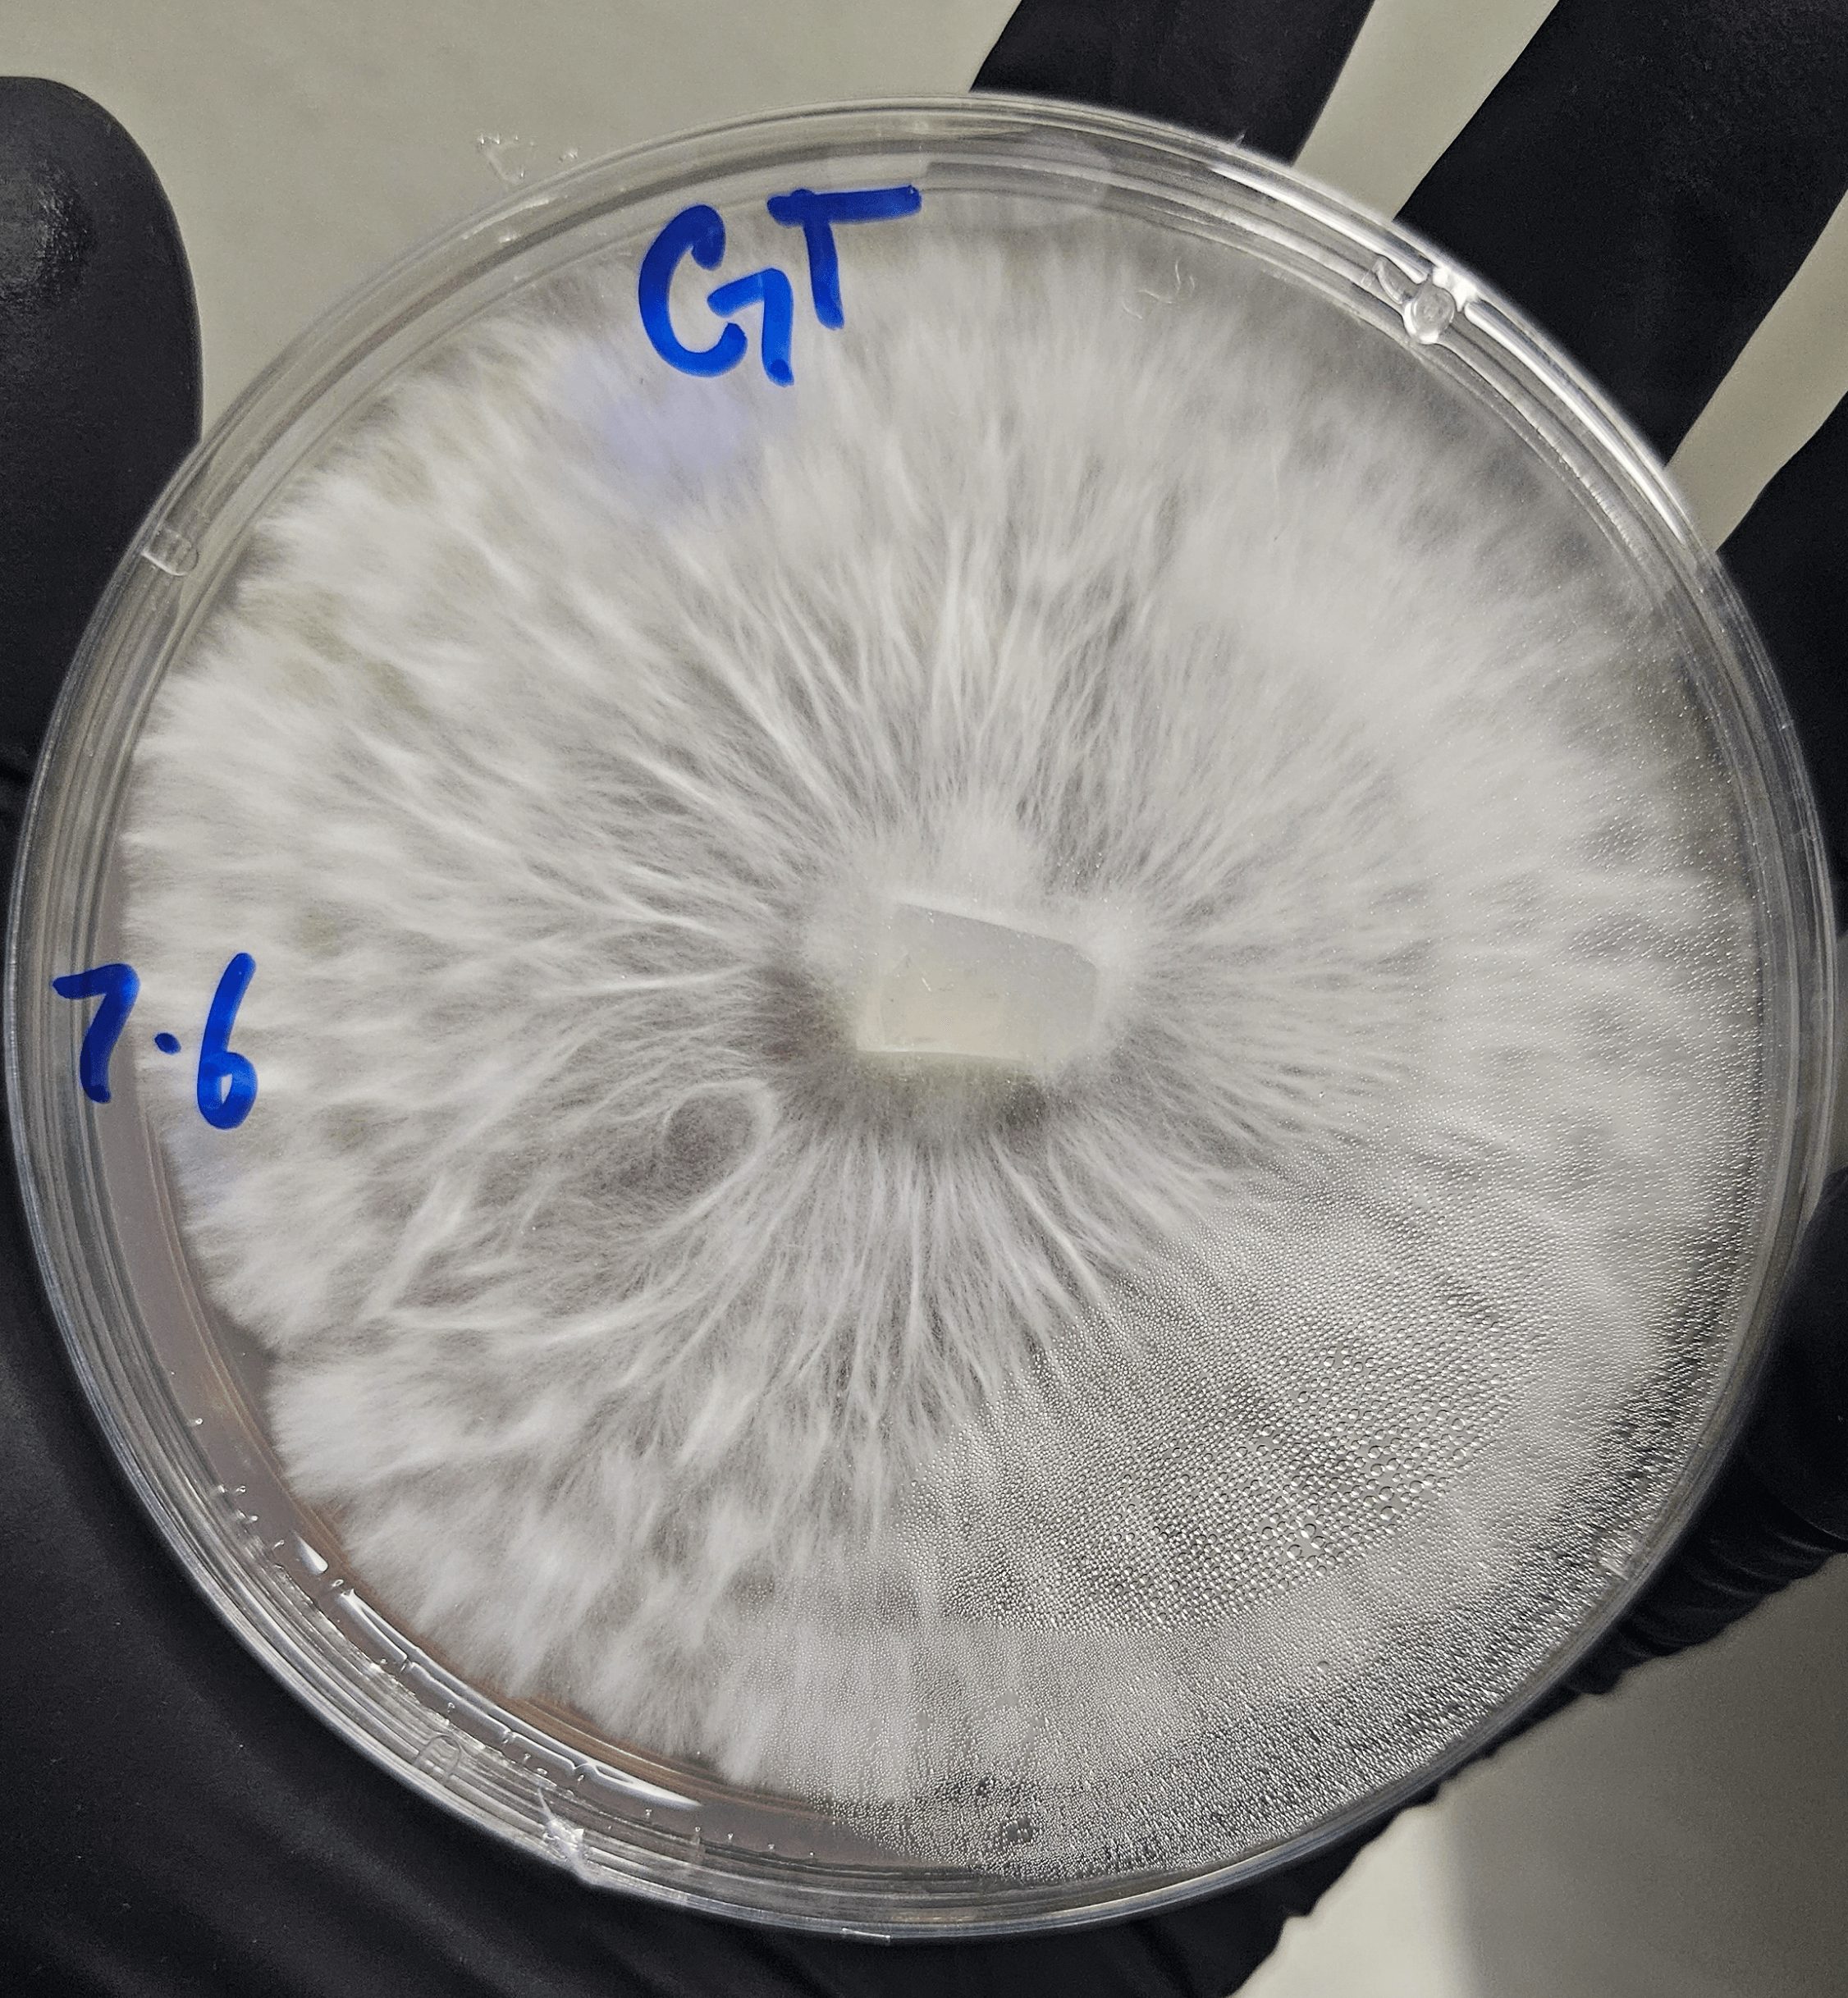

Today we’d like to introduce you to Fabian Retana
Hi Fabian , we’d love for you to start by introducing yourself.
My name is Fabian Retana, My journey started with an unexpected multiple sclerosis diagnosis. In 2018 i was unexpectedly diagnosed with Multiple Sclerosis. i was told that statistically i was the last person they would expect to see, being a male in my early 20’s and Hispanic wasn’t impossible but not an every day occurrence. I ended up getting almost every symptom one could think of. speech problems, loss of mobility from my waist down, loss of muscular strength in my left eye ( optic neuritis), and oversensitivity just to name a few.
I had a lot to process once i got hit with the official diagnosis . Learning to deal with a new and scary diagnosis while also trying to lead the life of a normal 23 year old proved more challenging then i expected. I endured trials of medications that gave me even worst symptoms and uncertainty. it really felt like my life was over as it was just beginning.
In 2019 I approached my neurologist in hopes to get these depressing and unsettling thoughts out of my head. unfortunately i was met with a list of anti depressants and a very typical doctor response to my mental health issues. I was convinced my hopes for a brighter tomorrow were over.
I talked to my girlfriend at the time (now wife) in a desperate cry for help, i mentioned psilocybin mushrooms. all the experiences with them i had as a teenager were very positive, and with al the fascinating new studies i kept seeing on depression and anxiety i was very open to the idea of trying a natural medicine.
After acquiring some mushrooms from friend and microdosing them in a medicinal way instead of recreational, I really started to notice a difference in my quality of life and the way i processed things. i almost didn’t believe the way my brain was processing and putting things together. i found beauty in my every day and i had patience with everything, but most importantly, myself. something in me understood that once this medicine was gone, I was never going to pay for it again. I had no idea how determined i was going to be in finding out what made these little Fun-gi’s tick.
During this cultivation journey i became obsessed with the culture, science and hobby of at home mycology. I started to understand that the mushrooms were giving me life just as mush as i was them.
Fast forward to 6 years. My Ms is in heavy remission, my brain legions are shrinking rapidly and I’ve fallen in love with myself and my life again. I knew that i needed to spread all this new found knowledge and excitement with everyone i also knew
suffered from any sort of mental health issues.
I’ve since then started a genetics company, teach grow classes, advocate for the use of natural medicine, and also grow for therapist and facilitators here in Colorado.
I Believe in a brighter future for mental health and the way we address and manage it in the future.
( I can’t say that it was all mushrooms, I’m also on a great medication for my Ms that i found after much trial and error.
I’m sure it wasn’t obstacle-free, but would you say the journey has been fairly smooth so far?
Far from a smooth road. Understanding that my life was never going to be the same was pretty tough. No one ever prepares you for the friendships you will lose either.
I guess over all the scariest thing might be the uncertainty of never knowing when i will get a flare up or how bad it will be. I live with those weird thoughts daily. As real as they are there, I’ve learned to give myself my sad time and keep it moving. I try to not let it consume my daily life.
Can you tell our readers more about what you do and what you think sets you apart from others?
In my daily life i work in a cannabis concentrates extraction lab. more specifically the solventless department, I’m either washing a high volume of cannabis using cold ice water to knock off the trichome heads, then dry freezing that and turning it into bubble hash or I’m turning that bubble hash into solventless hash rosin.
making rosin involves packing the bubble hash into fine mesh bags they are used to filter out any micro contaminates that might have gotten through the washing process, plant material for example. Then taking those bags then using a heated press with steel plates adding tons of pressure turns the the bubble hash bags into vaporizable hash rosin, ill take those weight and record them before and after in a spreadsheet to collect data on different strains being brought into the building,
Once i clock out, I got home where i run and manage Chronic cubez spore house. We specialize in stabilization and long term storage of mushrooms genetics, while also offering everything else you need to start your own at home mycology journey. We have vended psychedelic events in Colorado including Denver Psycon, and Denver ShroomFest, Even spreading harm reduction information at healing events such as sound baths and healing center pop ups.
Is there a quality that you most attribute to your success?
I’m far from successful, but my drive comes from helping people love their life, just like everyone deserves.
Pricing:
- Isolated syringes for cultivation $20
- all in one grow bags $35
- 3lb grow bag $30
- Substrate 6lbs $30
- consultations $50/ 1sthr $100/hr after that
Contact Info:
- Website: https://www.Chronic-cubez.com
- Instagram: Chronic_cubez

Image Credits
Fabian Retana
Menu and website made by Anna Lam



















